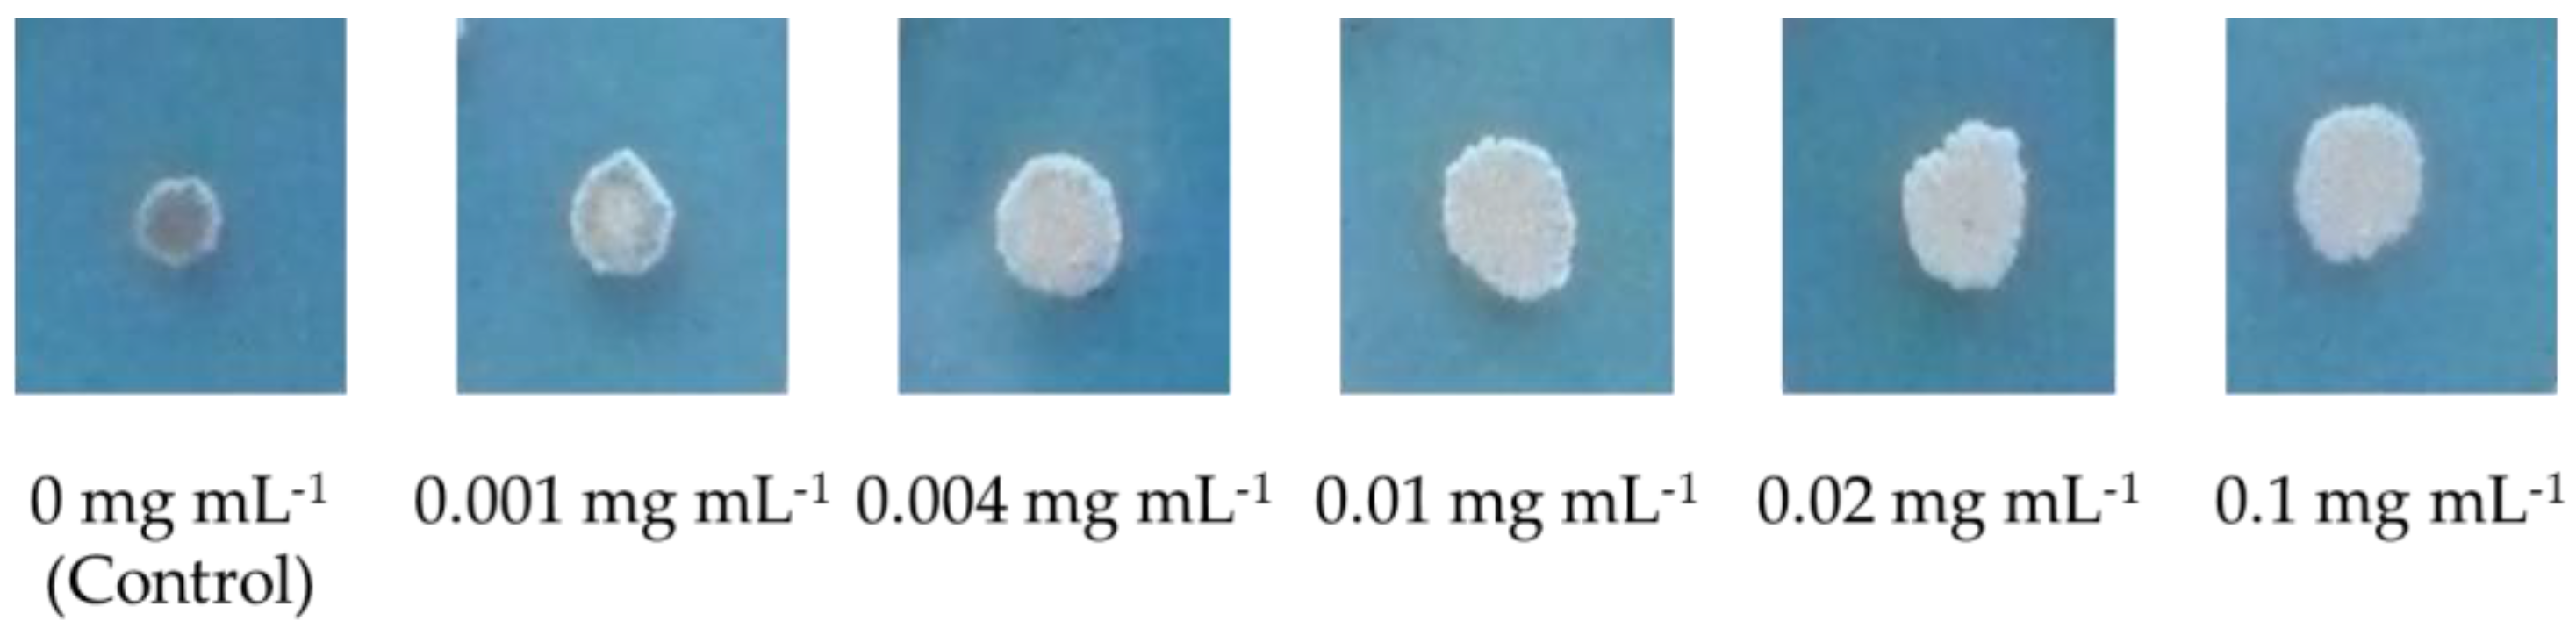

Surfactin Protects Wheat against Zymoseptoria tritici and Activates Both Salicylic Acid- and Jasmonic Acid-Dependent Defense Responses
Abstract
1. Introduction
2. Materials and Methods
2.1. Plant and Fungal Materials
2.2. Screening Trials
2.2.1. Treatment Preparation
2.2.2. Plant Treatment, Inoculation, and Infection Level Assessment
2.3. In Vitro Sensitivity Bioassay
2.4. Determination of Defense Gene Induction in Wheat
2.4.1. Plant Treatment
2.4.2. RNA Extraction and Quantification of Gene Expression by Quantitative RT-PCR
3. Results
3.1. Screening and Biocidal Results
3.2. Induction of Defense Responses
4. Discussion
5. Conclusions
Acknowledgments
Author Contributions
Conflicts of Interest
References
- Mejía-Teniente, L.; Torres-Pacheco, I.; González-Chavira, M.M.; Ocampo-Velazquez, R.V.; Herrera-Ruiz, G.; Chapa-Oliver, A.M.; Guevara-González, R.G. Use of elicitors as an approach for sustainable agriculture. Afr. J. Biotechnol. 2010, 9, 9155–9162. [Google Scholar]
- Walters, D.R.; Newton, A.C.; Lyon, G.D. Induced Resistance for Plant Defense: A Sustainable Approach to Crop Protection, 2nd ed.; Walters, D.R., Newton, A.C., Lyon, G.D., Eds.; Wiley-Blackwell: Oxford, UK, 2014; p. 352. [Google Scholar]
- Le Mire, G.; Nguyen, M.; Fassotte, B.; Du Jardin, P.; Verheggen, F.; Delaplace, P.; Jijakli, M. Implementing plant biostimulants and biocontrol strategies in the agroecological management of cultivated ecosystems. A review. Biotechnol. Agron. Soc. Environ. 2016, 20, 299–313. [Google Scholar]
- Schwessinger, B.; Ronald, P.C. Plant innate immunity: Perception of conserved microbial signatures. Annu. Rev. Plant Biol. 2012, 63, 451–482. [Google Scholar] [CrossRef] [PubMed]
- Thakur, M.; Sohal, B.S. Role of elicitors in inducing resistance in plants against pathogen infection: A Review. ISRN Biochem. 2013, 2013. [Google Scholar] [CrossRef] [PubMed]
- Walters, D.R.; Ratsep, J.; Havis, N.D. Controlling crop diseases using induced resistance: Challenges for the future. J. Exp. Bot. 2013, 64, 1263–1280. [Google Scholar] [CrossRef] [PubMed]
- Henry, G.; Deleu, M.; Jourdan, E.; Thonart, P.; Ongena, M. The bacterial lipopeptide surfactin targets the lipid fraction of the plant plasma membrane to trigger immune-related defence responses. Cell. Microbiol. 2011, 13, 1824–1837. [Google Scholar] [CrossRef] [PubMed]
- Ongena, M.; Jacques, P. Bacillus lipopeptides: Versatile weapons for plant disease biocontrol. Trends Microbiol. 2008, 16, 115–125. [Google Scholar] [CrossRef] [PubMed]
- Jacques, P. Surfactin and other lipopeptides from Bacillus spp. In Biosurfactants; Soberón-Chávez, G., Ed.; Microbiology Monographs; Springer: Berlin/Heidelberg, Germany, 2011; pp. 57–91. ISBN 978-3-642-14489-9. [Google Scholar]
- Henry, G. Study of the Induced Systemic Resistance of Plants: Molecular Aspects of the Interaction between Plant Cells and Amphiphilic Elicitors Produced by Non-Pathogenic Rhizobacteria. Ph.D. Thesis, Université de Liège—Gembloux Agro-BioTech, Gembloux, Belgium, 2013. [Google Scholar]
- Cawoy, H.; Mariutto, M.; Henry, G.; Fisher, C.; Vasilyeva, N.; Thonart, P.; Dommes, J.; Ongena, M. Plant defense stimulation by natural isolates of Bacillus depends on efficient surfactin production. Mol. Plant-Microbe Interact. 2014, 27, 87–100. [Google Scholar] [CrossRef] [PubMed]
- Raaijmakers, J.M.; de Bruijn, I.; Nybroe, O.; Ongena, M. Natural functions of lipopeptides from Bacillus and Pseudomonas: More than surfactants and antibiotics. FEMS Microbiol. Rev. 2010, 34, 1037–1062. [Google Scholar] [CrossRef] [PubMed]
- Ongena, M.; Jourdan, E.; Adam, A.; Paquot, M.; Brans, A.; Joris, B.; Arpigny, J.L.; Thonart, P. Surfactin and fengycin lipopeptides of Bacillus subtilis as elicitors of induced systemic resistance in plants. Environ. Microbiol. 2007, 9, 1084–1090. [Google Scholar] [CrossRef] [PubMed]
- Jourdan, E.; Henry, G.; Duby, F.; Dommes, J.; Barthélemy, J.P.; Thonart, P.; Ongena, M. Insights into the defense-related events occurring in plant cells following perception of surfactin-type lipopeptide from Bacillus subtilis. Mol. Plant-Microbe Interact. 2009, 22, 456–468. [Google Scholar] [CrossRef] [PubMed]
- Desoignies, N.; Schramme, F.; Ongena, M.; Legrève, A. Systemic resistance induced by Bacillus lipopeptides in Beta vulgaris reduces infection by the rhizomania disease vector Polymyxa betae. Mol. Plant Pathol. 2013, 14, 416–421. [Google Scholar] [CrossRef] [PubMed]
- Balmer, D.; Planchamp, C.; Mauch-Mani, B. On the move: Induced resistance in monocots. J. Exp. Bot. 2013, 64, 1249–1261. [Google Scholar] [CrossRef] [PubMed]
- Fones, H.; Gurr, S. The impact of Septoria tritici Blotch disease on wheat: An EU perspective. Fungal Genet. Biol. 2015, 79, 3–7. [Google Scholar] [CrossRef] [PubMed]
- Satger, O. L’offre Mondiale Excédentaire en 2015/2016 et la Perspective de Bonnes Récoltes en 2016 Continuent de Faire Pression sur Les Prix des Grains. Agreste 2016, 287. Available online: http://agreste.agriculture.gouv.fr/IMG/pdf/conjsynt287201605cult.pdf (accessed on 16 September 2016).
- Torriani, S.F.F.; Melichar, J.P.E.; Mills, C.; Pain, N.; Sierotzki, H.; Courbot, M. Zymoseptoria tritici: A major threat to wheat production, integrated approaches to control. Fungal Genet. Biol. 2015, 79, 8–12. [Google Scholar] [CrossRef] [PubMed]
- Maufras, J.-Y.; Maumené, C. Septoriose sur Les Blés: Une Nuisibilité Record Dans le Nord et l’Est. Perspect. Agric. 2016, 439. Available online: https://www.perspectives-agricoles.com/file/galleryelement/pj/46/dd/8a/4a/439_3157531144777164358.pdf (accessed on 13 February 2017).
- Palmer, C.L.; Skinner, W. Mycosphaerella graminicola: Latent infection, crop devastation and genomics. Mol. Plant Pathol. 2002, 3, 63–70. [Google Scholar] [CrossRef] [PubMed]
- Fraaije, B.A.; Cools, H.J.; Fountaine, J.; Lovell, D.J.; Motteram, J.; West, J.S.; Lucas, J.A. Role of ascospores in further spread of QoI-resistant cytochrome b alleles (G143A) in field populations of Mycosphaerella graminicola. Phytopathology 2005, 95, 933–941. [Google Scholar] [CrossRef] [PubMed]
- Brisset, M.-N.; Duge De Bernonville, T. Device for Determining or Studying the State of Stimulation of the Natural Defences of Plants or Portions of Plants. 2011. Available online: https://patentscope.wipo.int/search/en/detail.jsfdocId=WO2011161388&recNum=210&docAn=FR2011051470&queryString=(CL/antibod*)%2520OR%2520(DE/antibod*)%2520OR%2520(ET/antibod*)%2520&maxRec=145490 (accessed on 27 May 2016).
- Dugé de Bernonville, T.; Marolleau, B.; Staub, J.; Gaucher, M.; Brisset, M.-N. Using molecular tools to decipher the complex world of plant resistance inducers: An apple case study. J. Agric. Food Chem. 2014, 62, 11403–11411. [Google Scholar] [CrossRef] [PubMed]
- Siah, A.; Deweer, C.; Morand, E.; Reignault, P.; Halama, P. Azoxystrobin resistance of French Mycosphaerella graminicola strains assessed by four in vitro bioassays and by screening of G143A substitution. Crop Prot. 2010, 29, 737–743. [Google Scholar] [CrossRef]
- Van Hulten, M.; Pelser, M.; Van Loon, L.C.; Pieterse, C.M.J.; Ton, J. Costs and benefits of priming for defense in Arabidopsis. Proc. Natl. Acad. Sci. USA 2006, 103, 5602–5607. [Google Scholar] [CrossRef] [PubMed]
- Walters, D.; Heil, M. Costs and trade-offs associated with induced resistance. Physiol. Mol. Plant Pathol. 2007, 71, 3–17. [Google Scholar] [CrossRef]
- Walters, D.R.; Paterson, L.; Walsh, D.J.; Havis, N.D. Priming for plant defense in barley provides benefits only under high disease pressure. Physiol. Mol. Plant Pathol. 2009, 73, 95–100. [Google Scholar] [CrossRef]
- Shetty, N.P.; Mehrabi, R.; Lütken, H.; Haldrup, A.; Kema, G.H.J.; Collinge, D.B.; Jørgensen, H.J.L. Role of hydrogen peroxide during the interaction between the hemibiotrophic fungal pathogen Septoria tritici and wheat. New Phytol. 2007, 174, 637–647. [Google Scholar] [CrossRef] [PubMed]
- Kuźniak, E.; Urbanek, H. The involvement of hydrogen peroxide in plant responses to stresses. Acta Physiol. Plant. 2000, 22, 195–203. [Google Scholar] [CrossRef]
- Weber, H. Fatty acid-derived signals in plants. Trends Plant Sci. 2002, 7, 217–224. [Google Scholar] [CrossRef]
- Vogt, T. Phenylpropanoid biosynthesis. Mol. Plant 2009, 3, 2–20. [Google Scholar] [CrossRef] [PubMed]
- Verhage, A.; Wees, A.C.M.; van Pieterse, C.M.J.; Verhage, A.; Wees, A.C.M.; van Pieterse, C.M.J. Plant immunity: It’s the hormones talking, but what do they say? Plant Physiol. 2010, 154, 536–540. [Google Scholar] [CrossRef] [PubMed]
- Wasternack, C.; Hause, B. Jasmonates: Biosynthesis, perception, signal transduction and action in plant stress response, growth and development. An update to the 2007 review in Annals of Botany. Ann. Bot. 2013, 111, 1021–1058. [Google Scholar] [CrossRef] [PubMed]
- Schmittgen, T.D.; Livak, K.J. Analyzing real-time PCR data by the comparative CT method. Nat. Protoc. 2008, 3, 1101–1108. [Google Scholar] [CrossRef] [PubMed]
- Yamamoto, S.; Shiraishi, S.; Suzuki, S. Are cyclic lipopeptides produced by Bacillus amyloliquefaciens S13–S3 responsible for the plant defence response in strawberry against Colletotrichum gloeosporioides? Lett. Appl. Microbiol. 2015, 60, 379–386. [Google Scholar] [CrossRef] [PubMed]
- Mejri, S.; Siah, A.; Coutte, F.; Magnin-Robert, M.; Randoux, B.; Tisserant, B.; Krier, F.; Jacques, P.; Reignault, P.; Halama, P. Biocontrol of the wheat pathogen Zymoseptoria tritici using cyclic lipopeptides from Bacillus subtilis. Environ. Sci. Pollut. Res. 2017, 1–12. [Google Scholar] [CrossRef] [PubMed]
- Walters, D.R.; Havis, N.D.; Paterson, L.; Taylor, J.; Walsh, D.J. Cultivar effects on the expression of induced resistance in spring barley. Plant Dis. 2011, 95, 595–600. [Google Scholar] [CrossRef]
- Ors, M.-E.; Siah, A.; Randoux, B.; Selim, S.; Couleaud, G.; Maumené, C.; Reignault, P.; Halama, P. Cultivar-dependent efficacy and mode of action of plant resistance inducers in wheat against Septoria tritici leaf blotch. IOBC-WPRS Bull. 2013, 89, 333–338. [Google Scholar]
- Tendulkar, S.R.; Saikumari, Y.K.; Patel, V.; Raghotama, S.; Munshi, T.K.; Balaram, P.; Chattoo, B.B. Isolation, purification and characterization of an antifungal molecule produced by Bacillus licheniformis BC98, and its effect on phytopathogen Magnaporthe grisea. J. Appl. Microbiol. 2007, 103, 2331–2339. [Google Scholar] [CrossRef] [PubMed]
- Wiesel, L.; Newton, A.C.; Elliott, I.; Booty, D.; Gilroy, E.M.; Birch, P.R.J.; Hein, I. Molecular effects of resistance elicitors from biological origin and their potential for crop protection. Front. Plant Sci. 2014, 5, 655. [Google Scholar] [CrossRef] [PubMed]
- Klarzynski, O.; Fritig, B. Stimulation des défenses naturelles des plantes. C. R. Acad. Sci. Ser. III Sci. Vie 2001, 324, 953–963. [Google Scholar] [CrossRef]
- Kärkönen, A.; Kuchitsu, K. Reactive oxygen species in cell wall metabolism and development in plants. Phytochemistry 2015, 112, 22–32. [Google Scholar] [CrossRef] [PubMed]
- Gozzo, F.; Faoro, F. Systemic acquired resistance (50 years after discovery): Moving from the lab to the field. J. Agric. Food Chem. 2013, 61, 12473–12491. [Google Scholar] [CrossRef] [PubMed]
- La Camera, S.; Gouzerh, G.; Dhondt, S.; Hoffmann, L.; Fritig, B.; Legrand, M.; Heitz, T. Metabolic reprogramming in plant innate immunity: The contributions of phenylpropanoid and oxylipin pathways. Immunol. Rev. 2004, 198, 267–284. [Google Scholar] [CrossRef] [PubMed]
- Glazebrook, J. Contrasting mechanisms of defense against Biotrophic and Necrotrophic pathogens. Annu. Rev. Phytopathol. 2005, 43, 205–227. [Google Scholar] [CrossRef] [PubMed]
- Van Loon, L.C.; Van Strien, E.A. The families of pathogenesis-related proteins, their activities, and comparative analysis of PR-1 type proteins. Physiol. Mol. Plant Pathol. 1999, 55, 85–97. [Google Scholar] [CrossRef]
- Ors, M.-E. Importance du Cultivar Dans la Résistance Induite par des Stimulateurs de Défense des Plantes vis-à-vis de Mycosphaerella graminicola, Agent Responsable de la Septoriose du blé. Ph.D. Thesis, Université du Littoral Côte d’Opale, Dunkerque, France, 2015. [Google Scholar]
- Ding, L.-N.; Yang, G.-X.; Yang, R.-Y.; Cao, J.; Zhou, Y. Investigating interactions of salicylic acid and jasmonic acid signaling pathways in monocots wheat. Physiol. Mol. Plant Pathol. 2016, 93, 67–74. [Google Scholar] [CrossRef]
- Garcia-Gutierrez, L.; Zeriouh, H.; Romero, D.; Cubero, J.; Vicente, A.; Perez-Garcia, A. The antagonistic strain Bacillus subtilis UMAF 6639 also confers protection to melon plants against cucurbit powdery mildew by activation of jasmonate- and salicylic acid-dependent defence responses. Microb. Biotechnol. 2013, 6, 264–274. [Google Scholar] [CrossRef] [PubMed]
- Tjamos, S.E.; Flemetakis, E.; Paplomatas, E.J.; Katinakis, P. Induction of resistance to Verticillium dahliae in Arabidopsis thaliana by the biocontrol agent K-165 and pathogenesis-related proteins gene expression. Mol. Plant-Microbe Interact. 2005, 18, 555–561. [Google Scholar] [CrossRef] [PubMed]
- Niu, D.-D.; Liu, H.-X.; Jiang, C.-H.; Wang, Y.-P.; Wang, Q.-Y.; Jin, H.-L.; Guo, J.-H. The plant growth-promoting rhizobacterium Bacillus cereus AR156 induces systemic resistance in Arabidopsis thaliana by simultaneously activating salicylate-and jasmonate/ethylene-dependent signaling pathways. Mol. Plant-Microbe Interact. 2011, 24, 533–542. [Google Scholar] [CrossRef] [PubMed]
- Niu, D.; Wang, C.-J.; Guo, Y.-H.; Jiang, C.-H.; Zhang, W.-Z.; Wang, Y.; Guo, J.-H. The plant growth-promoting rhizobacterium Bacillus cereus AR156 induces resistance in tomato with induction and priming of defence response. Biocontrol Sci. Technol. 2012. [Google Scholar] [CrossRef]
- Ongena, M.; Duby, F.; Rossignol, F.; Fauconnier, M.-L.; Dommes, J.; Thonart, P. Stimulation of the lipoxygenase pathway is associated with systemic resistance induced in bean by a nonpathogenic Pseudomonas strain. Mol. Plant-Microbe Interact. 2004, 17, 1009–1018. [Google Scholar] [CrossRef] [PubMed]
- Conrath, U.; Thulke, O.; Katz, V.; Schwindling, S.; Kohler, A. Priming as a mechanism in induced systemic resistance of plants. Eur. J. Plant Pathol. 2011, 107, 113–119. [Google Scholar] [CrossRef]
- Denancé, N.; Sánchez-Vallet, A.; Goffner, D.; Molina, A. Disease resistance or growth: The role of plant hormones in balancing immune responses and fitness costs. Front. Plant Sci. 2013, 4. [Google Scholar] [CrossRef] [PubMed]
- Dolferus, R. To grow or not to grow: A stressful decision for plants. Plant Sci. Int. J. Exp. Plant Biol. 2014, 229, 247–261. [Google Scholar] [CrossRef] [PubMed]
- Görlach, J.; Kessmann, H.; Ryals, J.; Volrath, S.; Knauf-Beiter, G.; Hengy, G.; Beckhove, U.; Kogel, K.H.; Oostendorp, M.; Staub, T.; et al. Benzothiadiazole, a novel class of inducers of systemic acquired resistance, activates gene expression and disease resistance in wheat. Plant Cell 1996, 8, 629–643. [Google Scholar] [CrossRef] [PubMed]
- Vallad, G.E.; Goodman, R.M. Systemic acquired resistance and induced systemic resistance in conventional agriculture. Crop Sci. 2004, 44, 1920–1934. [Google Scholar] [CrossRef]
- Hofgaard, I.S.; Ergon, Å.; Wanner, L.A.; Tronsmo, A.M. The effect of chitosan and Bion on resistance to pink snow mould in perennial ryegrass and winter wheat. J. Phytopathol. 2005, 153, 108–119. [Google Scholar] [CrossRef]
- Beckers, G.J.; Conrath, U. Priming for stress resistance: From the lab to the field. Curr. Opin. Plant Biol. 2007, 10, 425–431. [Google Scholar] [CrossRef] [PubMed]
- Kogel, K.-H.; Langen, G. Induced disease resistance and gene expression in cereals. Cell. Microbiol. 2005, 7, 1555–1564. [Google Scholar] [CrossRef] [PubMed]
- Ozeretskovskaya, O.; Vasyukova, N. The use of elicitors for protection of cultured plants demands caution. Appl. Biochem. Microbiol. 2002, 38, 277–279. [Google Scholar] [CrossRef]

© 2018 by the authors. Licensee MDPI, Basel, Switzerland. This article is an open access article distributed under the terms and conditions of the Creative Commons Attribution (CC BY) license (http://creativecommons.org/licenses/by/4.0/).
Share and Cite
Le Mire, G.; Siah, A.; Brisset, M.-N.; Gaucher, M.; Deleu, M.; Jijakli, M.H. Surfactin Protects Wheat against Zymoseptoria tritici and Activates Both Salicylic Acid- and Jasmonic Acid-Dependent Defense Responses. Agriculture 2018, 8, 11. https://doi.org/10.3390/agriculture8010011
Le Mire G, Siah A, Brisset M-N, Gaucher M, Deleu M, Jijakli MH. Surfactin Protects Wheat against Zymoseptoria tritici and Activates Both Salicylic Acid- and Jasmonic Acid-Dependent Defense Responses. Agriculture. 2018; 8(1):11. https://doi.org/10.3390/agriculture8010011
Chicago/Turabian StyleLe Mire, Geraldine, Ali Siah, Marie-Noëlle Brisset, Matthieu Gaucher, Magali Deleu, and M. Haissam Jijakli. 2018. "Surfactin Protects Wheat against Zymoseptoria tritici and Activates Both Salicylic Acid- and Jasmonic Acid-Dependent Defense Responses" Agriculture 8, no. 1: 11. https://doi.org/10.3390/agriculture8010011
APA StyleLe Mire, G., Siah, A., Brisset, M.-N., Gaucher, M., Deleu, M., & Jijakli, M. H. (2018). Surfactin Protects Wheat against Zymoseptoria tritici and Activates Both Salicylic Acid- and Jasmonic Acid-Dependent Defense Responses. Agriculture, 8(1), 11. https://doi.org/10.3390/agriculture8010011
